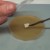

Introduction:
Lorsqu’on utilise une seringue de spores pour l’inoculation, beaucoup de mycéliums différents vont se développer et entrer en concurrence afin de puiser la nourriture contenue dans le substrat. L’avantage de réaliser un clonage de tissu d’un champignon est justement de ne conserver qu’un individu et donc un seul mycélium. Sans concurrence celui-ci sera beaucoup plus rapide pour coloniser le substrat.
Cette manipulation est simple à réaliser, toute la difficulté est de réussir à garder un maximum de stérilité durant chaque étape du processus. Pour mettre toute les chances de votre côté lisez: 7 conseils pour un maximum de stérilité et les 6 vecteurs de contaminations.
Le but de cette technique est de prélever stérilement un morceau de chair à l’intérieur du champignon et de le déposer sur un substrat stérile (culture liquide, céréales ou milieu gélosé) afin de produire du mycélium.
Le mieux est de choisir un champignon jeune (ayant encore le chapeau fermé) et vigoureux car vos futures récoltes dépendront de cet individu. Vous pouvez aussi vous servir d’un champignon acheté dans le commerce afin de cloner la souche et de la cultiver.
Manipulation:
 Prenez un beau et jeune champignon,
Prenez un beau et jeune champignon,
 et sectionnez-le en deux dans le sens de la longueur.
et sectionnez-le en deux dans le sens de la longueur.
 Chauffez la lame de votre scalpel à rouge et laissez la refroidir quelques secondes (attention à ne pas tuer le tissu en le brulant) avant de prélever un petit morceau de chair à la base du chapeau (un carré de 2-3 millimètres de côté). En effet, un gros morceau de tissu augmenterait les risques de contaminations: plus la surface de prélèvement est grande et plus il y a de chances pour qu’elle soit contaminée.
Chauffez la lame de votre scalpel à rouge et laissez la refroidir quelques secondes (attention à ne pas tuer le tissu en le brulant) avant de prélever un petit morceau de chair à la base du chapeau (un carré de 2-3 millimètres de côté). En effet, un gros morceau de tissu augmenterait les risques de contaminations: plus la surface de prélèvement est grande et plus il y a de chances pour qu’elle soit contaminée.
 Il ne vous reste plus qu’à déposer ce petit morceau dans votre substrat stérile (céréales, culture liquide ou milieu gélosé)
Il ne vous reste plus qu’à déposer ce petit morceau dans votre substrat stérile (céréales, culture liquide ou milieu gélosé)
 Placez ensuite le substrat dans votre incubateur.
Placez ensuite le substrat dans votre incubateur.
Photos du site : www.fungifun.org
Autres articles à consulter:
- Clonage et culture de mycélium sur carton à partir d'un champignon
- Comment réaliser une culture liquide ?
- Comment inoculer un milieu de culture en gélose?

(27 commentaires)
Passer au formulaire de commentaire ↓
Laurent D.
22 novembre 2011 à 22 h 07 min (UTC 2) Lier vers ce commentaire
Je constate que vous ne prélevez qu’un tout petit morceau du chapeau. Est-ce qu’il y a une raison particulière à cela?
Car on pourrait penser qu’en prélevant une plus grande partie du chapeau, on aura d’avantage de spores potentiels prêts à produire du mycélium (ce qui est peut-être totalement faux).
Enfin, est-ce qu’il faut obligatoirement prélever un morceau du chapeau se situant juste au dessus de la partie sombre comme vous l’avez fait? Ou peut-on retirer n’importe quelle partie du chapeau? Je vous pose cette question car j’imagine facilement un prélèvement sur un champignon de Paris, mais j’ai beaucoup plus de mal à imaginer la façon de faire un prélèvement sur une pleurote par exemple.
Merci d’avance pour vos précisions!
PS: Comme dit dans nos échanges de mails: je salue pour votre initiative et vous encourage pour la suite! Vous faites vraiment du bon travail!
Samuel
23 novembre 2011 à 14 h 06 min (UTC 2) Lier vers ce commentaire
Un grand morceau de chair permettrait un développement plus rapide mais augmenterait grandement les risques de contamination alors qu’un petit morceau et largement suffisant pour que le mycélium se développe. Le but n’est pas de recueillir des spores mais uniquement un morceau de chair (qui est du mycélium condensé) et de le « repiquer » dans la culture liquide ou un autre support.
Deux parties sont à privilégier pour effectuer le prélèvement en raison de leur concentration élevée en cellule souche: la base du pied et le centre du chapeau. Tu dois prélever à un de ces deux endroits le plus au centre possible afin d’éviter au maximum les éventuels contaminants se trouvant sur la partie externe du champignon.
Laurent D.
23 novembre 2011 à 14 h 32 min (UTC 2) Lier vers ce commentaire
Tout est clair du coup! C’est le genre de précision qui aurait, il me semble, sa place dans votre article car un novice comme moi sera tenté de prélever un plus gros morceau de chapeau pensant augmenter ses chances de réussite, ce qui est tout le contraire.
Simon
22 mars 2012 à 18 h 13 min (UTC 2) Lier vers ce commentaire
Est-ce qu’on peut utiliser un champignon sécher pour le clonage ?
Samuel
22 mars 2012 à 19 h 00 min (UTC 2) Lier vers ce commentaire
Non, il faut absolument utiliser un champignon frais pour réaliser un clonage, ses tissus doivent être encore vivants. Un champignon séché contient des spores qui peuvent germer mais le risque de contaminations est élevé.
Toitoine
20 avril 2012 à 9 h 47 min (UTC 2) Lier vers ce commentaire
Hello,
J’ai testé cette technique pour des pleurottes et champi de paris.
Le mélange était à base d’agar, patate et glucose.
Résultat, aucun développement, ni des champis, ni moisisure de contamination ou autre 🙁
A quoi ca peut être du ? Les champis étaient bien frais pourtant ?!
Merci
Samuel
20 avril 2012 à 13 h 09 min (UTC 2) Lier vers ce commentaire
Bonjour,
Lorsque le scalpel est mal refroidi, il peut tuer le tissu du champignon ce qui empêchera le développement du mycélium.
Pour savoir si le problème vient de la manipulation ou du milieu de culture, je vous recommande d’ouvrir une boite de Pétri afin de « provoquer » une contamination (ou de poser votre doigt sur la gélose pour être sur de la contaminer), puis de la replacer en incubation. Si toujours rien ne se développe, cela serait signe d’un problème dans la gélose. Une stérilisation trop longue peut dégrader les ingrédients du milieu gélosé. J’espère vous avoir aider à identifier le problème.
Amicalement,
Samuel
Toitoine
20 avril 2012 à 17 h 24 min (UTC 2) Lier vers ce commentaire
Merci pour la réponse.
Pour le cutter, je l’ai désinfecté à l’alcool. Mauvaise idée ?
Parcontre je ne pense pas avoir trop « cuit » le mélange.
Peut-etre un mauvais dosage ?
Je vais tenter la contamination volontaire.
Merci,
Toitoine
Samuel
20 avril 2012 à 19 h 03 min (UTC 2) Lier vers ce commentaire
Bonsoir,
Il est préférable de stériliser à la flamme mais l’alcool convient aussi. En tout cas le problème ne vient pas du tissu qui aurait brulé après un mauvais refroidissement. Il doit y avoir un soucis dans la gélose mais ce n’est pas évident de savoir ce qui n’a pas marché. Vérifiez que les ingrédients que vous avez utilisés ne contiennent pas de conservateur ou de fongicide.
sana
3 juillet 2012 à 14 h 26 min (UTC 2) Lier vers ce commentaire
bonjour samuel.
un clonage donne t-il du mycelium rhizomorphe?
Samuel
9 septembre 2012 à 18 h 38 min (UTC 2) Lier vers ce commentaire
Bonjour,
La plupart du temps le mycélium obtenu est rhizomorphique bien que certaines espèces produisent qu’un mycélium cotonneux. Les meilleurs résultats sont obtenus en clonant un champignon « jeune ». Je crois (à confirmer) que si les tissus du champignon cloné sont vieux, le mycélium obtenu peut manquer de vitalité.
tinobambino
8 novembre 2012 à 16 h 02 min (UTC 2) Lier vers ce commentaire
Bonjour Samuel, ce blog est très intéressant, et j’avoue avoir envie de me lancer dans la culture de champignons maisons.
Mon but est simple, réaliser une culture de champignons de Paris, sans acheter de kit, et faire perdurer longtemps dans le temps les différentes cultures. J’ai lu à peu près tous les articles et les différentes techniques pour mener à bien mon projet, mais j’ai des moyens limités (pas trop de sous, et pas trop envie d’acheter tout un tas de matos).
Mon objectif est donc d’acheter une boite de champignons de Paris dans le commerce, et de réaliser un clonage à partir d’un morceau champignon.
Je voulais donc savoir si je pouvais directement poser (et où dans le bocal?) le morceau de champignon sur des céréales (sans passer par le milieu de culture en gélose) ou directement mettre le morceau en milieu liquide (quel est le plus simple?). Du mycélium peut-il se former avec cette méthode?.
Puis-je réaliser une culture sans incubateur (quelle différence dans le temps cela fait-il?). Je précise que j’ai à disposition du fumier pour la suite du procédé, comment puis-je m’en servir?
Je suis vraiment intéressé mais comme tu peux t’en rendre compte je pars de zéro, donc merci de m’éclairer.
Samuel
10 novembre 2012 à 22 h 57 min (UTC 2) Lier vers ce commentaire
Bonjour Tino,
Franchement pour commencer je te recommande plutôt de commencer par des pleurotes. Les champignons de Paris ont besoin d’un substrat composté et d’une couche de gobetage (2 difficultés qui augmentent les chances que la culture soit contaminée).
Après pour produire ton mycélium, tu as besoin d’un minimum de stérilité dans tes manipulations. Les céréales sont très nutritives et donc très sensibles aux contaminants et inoculées avec un champignon du commerce non stérile… L’agar-agar permet justement d’obtenir une culture de mycélium pure.
Tu peux toujours essayer, c’est tout à fait possible mais reste à voir le % de réussite…
Bon courage pour tes essais Tino
nachtergaele
27 novembre 2012 à 21 h 05 min (UTC 2) Lier vers ce commentaire
bonjour comment réaliser le substrat de culture et l’incubateur doit faire comment j’aimerai plus d’explication merci et bien a vous
Samuel
6 décembre 2012 à 14 h 50 min (UTC 2) Lier vers ce commentaire
Bonjour,
Je vous recommande la lecture de cet article pour l’incubateur:
–Fabriquer un incubateur
Et pour réaliser le substrat de culture, j’ai besoin de connaitre l’espèce que vous désirez cultiver.
Bonne journée
Aissam
24 décembre 2012 à 9 h 52 min (UTC 2) Lier vers ce commentaire
Bonjour,
tout d’abord ,je vous remercie infiniment pour vos explication ,c’est grâce à vous que je veux commencer la culture des champignons de paris.
j’ai commencer par la la culture du mycélium sur Agar agar (j’ai choisi le melange agar agar -croquette de chien),et j’ai mis les boites dans un incubateur (25°) ?et je voudrai savoir s’il faut fermé les boites avec un film ou bien non ?j’ai suivi toute vos instructions .Et merci.
Samuel
8 janvier 2013 à 0 h 54 min (UTC 2) Lier vers ce commentaire
Bonsoir Aissam,
Merci pour vos encouragements!
L’utilisation d’un film est possible: avantage: limite les contaminations inconvénient: limite l’échange gazeux et peut ralentir légèrement le développement du mycélium.
Bon courage pour vos essais!
yannick D
7 janvier 2013 à 23 h 05 min (UTC 2) Lier vers ce commentaire
bonjour.
j essais de cloner un champignon de paris dans une culture liquide.
ma question est la suivante: combien de temps apres l innoculation du morceau de champignon dans le liquide le mycelium commence a apparaitre?
j utilise de l eau et du miel comme melange. je me suis fabriqué un incubateur, un scalpel, une seringue… j suis comme un gosse qui attend que ca marche, surement trop impacient alors svp alimentez ma pacience…
ah et deuxieme question… qui a réussis a cloner d autres champignons que ceux només sur le cite? cepes morilles lactaires???
merci pour vos réponses…
et bravo pour le cite 😉
Samuel
8 janvier 2013 à 2 h 10 min (UTC 2) Lier vers ce commentaire
Bonsoir Yannick,
En général, le mycélium commence à se développer entre 48 à 72 heures après l’inoculation de la culture liquide.
Mais il est plus facile de réaliser un clonage sur un milieu gélosé.
Pour ce qui est de votre deuxième question, j’ai déjà réussi à cloner une morille afin de produire du mycélium. Je pense que c’est aussi facile pour les cèpes et les lactaires… Mais le plus dur est d’obtenir la fructification de l’espèce et non de produire le mycélium.
Bon courage pour vos essais et n’hésitez pas si vous avez d’autres questions!
6RDEK
23 janvier 2013 à 20 h 40 min (UTC 2) Lier vers ce commentaire
est ce que ça marcherai avec de la morille?
Merci pour toutes les infos.
Samuel
23 janvier 2013 à 22 h 52 min (UTC 2) Lier vers ce commentaire
Bonsoir,
Cette technique fonctionne très bien avec les morilles 😉 Leur mycélium est particulièrement rapide (je dirais même que c’est le mycélium le plus rapide que j’ai jamais vu).
Par contre il faudra encore attendre un peu pour la saison des morilles 🙂 Un clonage effectué sur un champignon « sauvage » a de grandes chances d’être contaminé. Tu devras probablement effectuer une sauvegarde du mycélium. bon courage pour tes essais
ric
24 mars 2013 à 18 h 00 min (UTC 2) Lier vers ce commentaire
Bonjour à tous je suis pisciculteur j ai 50 m2 de cave sous des bassins c est humide avec en hiver 10 degrès et en été 20 degrès. Que puis-je y faire pousser? je vais essayer des pivoulades et des pleurotes ma clientèle est présente de juin à novembre. Quelqu’un peut il me vendre du mycélium? Me filer un coup de mains, je suis à Béziers, voir http://caylus.centerblog.net/
Samuel
25 mars 2013 à 12 h 19 min (UTC 2) Lier vers ce commentaire
Bonjour Ric,
Je trouve votre blog et votre activité très intéressante! Les températures de vos caves vous permettent de cultiver plusieurs espèces (champignons de Paris, pleurotes et d’autres espèces: pour en savoir plus, consultez les paramètres de culture de chaque espèce cultivable). Vous pouvez acheter du mycélium chez notre fournisseur. Bon courage pour vos essais!
yabi fondé yao
11 avril 2014 à 2 h 01 min (UTC 2) Lier vers ce commentaire
je cultive les champignons type pleurotus.je veux faire des expériences sur d’autres champignons.J’ai besoin d’aide pour avoir le mycélium et des conseilles pour la réussite.
chris
25 avril 2014 à 13 h 42 min (UTC 2) Lier vers ce commentaire
Bonjour ,
Fascinant votre site , bon connaisseur et amateur de champignons sauvages depuis des lustres , je m’était toujours demandé quels champignons je pourrais « cloner » et votre site réponds a beaucoup de mes questions , j’avais déjà obtenu des pleurotes en insérant des chevilles du commerce dans des buches de bois fraichement coupés .(d’autres poussaient accidentellement dans l’ombre de mon composteur )
Vous n’aurez peu être pas la réponse mais je la pose tout de même , parmi mes champignons sauvages préférés il y a les pieds Bleus( lepista nuda) et les cèpes (boletus edulis) en tous genres ,cèpes des pins , coulemelles , grisets .
Lesquels avez vous pu reproduire a l’état comestible ??
Merci
dassonneville
15 décembre 2015 à 15 h 49 min (UTC 2) Lier vers ce commentaire
superbe sujet très instructif, je vais essayé également de reproduire mon mycélium de champignons car je possède une cave humide a température de 12 à15°
Pappalardo
7 juin 2016 à 21 h 53 min (UTC 2) Lier vers ce commentaire
L’idée me paraît géniale comme toutes ces choses naturelles et saines qu’on oublie, merci … On va essayer